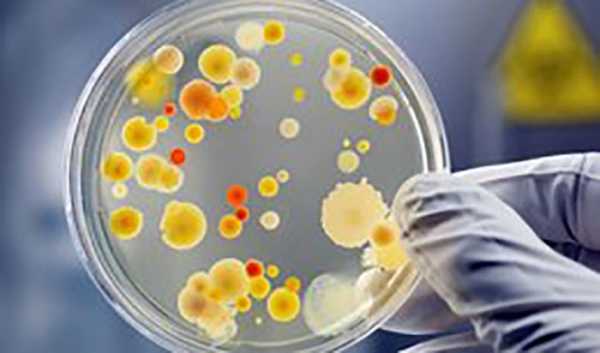

Середньовічне зілля тисячолітньої давності під назвою «Очна мазь Лисого» допомагає вченим лікувати інфекцію у 2020 році! Рукописи X століття знайшли в Британській бібліотеці. Вчені були приголомшені здатністю цих давніх ліків знищувати інфекції. Серія випробувань проходила у Великій Британії та США протягом усього минулого року.

Цей стародавній рецепт своєю ефективністю просто відкрив британським ученим очі! У складі зілля є вино, що не має нічого дивного. Загалом рецепт суміші схожий на кулінарний. Зілля відтворювали із звичайних продуктів, куплених у найближчому супермаркеті чи овочевому магазині. Вино використали англійське біле. У рецепті були цибуля, часник, жовчні солі. Останні були отримані від корів.

Книга Лисого, медичний текст 10-го століття, який містить англосаксонські медичні поради та рецепти ліків, мазей та лікарських засобів.
Ліки показали дивовижну ефективність у боротьбі з «біоплівками», що є по суті стійким скупченням бактерій. Зазвичай це величезна кількість бактерій, що накопичуються в одному місці. Біоплівки є серйозним головним болем для лікарів. Для боротьби з ними потрібна концентрація антибіотика в 100-1000 разів вище, ніж зазвичай.

Ефективність засобу перевищує стандартну концентрацію антибіотика у 100, а то й у 1000 разів.
На жаль, у наші дні інфекції стають все більш стійкими до сучасних медичних засобів. Це ж зілля з темних століть стало смертю для сучасної стійкої до метициліну інфекції Staphylococcus aureus (MRSA). Вчені були «приголомшені» смертоносною здатністю цих древніх ліків від очних інфекцій, що сходить до 10-го століття.

Вік чарівного зілля перевищує 1000 років.
Під час зустрічі вчених, які цікавляться інфекційними захворюваннями, доктор Крістіна Лі, фахівець із давньоанглійської мови, розповіла мікробіологам про книгу Bald's Leechbook. Це англосаксонський медичний підручник, що зберігається у Британській бібліотеці. У ньому містяться засоби лікування різних інфекцій та інших захворювань.

Книга лікувальних рецептів зберігалася у Британській бібліотеці.
За словами провідного дослідника доктора Фрей Харрісон, мікробіолога з Ноттінгемського університету, ці ліки тисячолітньої давності виявилися «неймовірно потужним» антибіотиком. Окремі інгредієнти власними силами не мали будь-якого вимірного ефекту, але у поєднанні, згідно з давнім текстом, вони вбили до 90 відсотків бактерій MRSA в інфікованих мишей. При інфекціях, вирощених у лабораторії, виживала приблизно одна бактеріальна клітина із тисячі.
При експериментах зілля показало себе фантастично ефективним – виживала приблизно одна бактерія із тисячі.
«Я досі не можу повірити, наскільки добре цей антибіотик тисячолітньої давності справді працює. Коли ми отримали перші результати, ми були просто приголомшені! Ми взагалі цього не очікували», – прокоментувала доктор Харрісон. Результати були представлені на щорічній конференції Товариства загальної мікробіології в Бірмінгемі і будуть представлені в глобальному науковому журналі Nature.

Флакони відтвореної мазі (Уорікський університет).
«Сучасні дослідження способів лікування хвороб можуть отримати користь з давніх віків і знань, які в основному містяться в ненаукових працях. Але потенціал цих текстів у вирішенні проблем неможливо зрозуміти і повною мірою оцінити без об'єднання досвіду як мистецтва, так і науки», – прокоментував доктор Лі.

Подібний прецедент із давніми рецептами науці вже знайомий.
Нестандартне мислення потребує величезних фінансових та, звичайно ж, людських витрат. За оцінками експертів, до 2050 року жертвою цієї проблеми можуть стати близько десяти мільйонів людей. Лікування цієї інфекції обходиться тільки Сполученому Королівству щороку більш ніж 1,3 мільярда доларів».
Середньовічний період та його незвичайні методи лікування раніше вивчалися Ноттінгемським університетом у зв'язку з MRSA. Мікробіолог Фрей Харрісон і компанія підхопили естафету за останні кілька років, опублікувавши результати своїх досліджень у журналі Scientific Reports.
Очна мазь Лисого успішно перемогла п'ять бактерій, що викликають біоплівку, включаючи бактерії, що викликають діабетичні інфекції стопи та виразки. Якщо їх не лікувати, вони можуть призвести до сепсису та ампутації. Що особливо інтригує, то це те, як ця очна мазь працює. Тільки точне дотримання цієї комбінації інгредієнтів, згідно з рецептом, здатне творити справжні дива!

Доктор Крістіна Лі (ліворуч) та доктор Андреа Кларк із Британської бібліотеки.
На основі цього середньовічного зілля за словами доктора Харрісон, можна розробити безпечний та ефективний антибактеріальний засіб. Подібний історичний прецедент уже є. Артемізінін ці ліки від малярії, які отримують з полину. Рецепт було знайдено в одному давньокитайському тексті. Без цього сучасне суспільство не змогло б настільки ефективно боротися проти цієї хвороби. В англосаксонському тексті також містяться згадки про полину як про ефективний засіб проти малярії.
У стерильних умовах сучасного стаціонару про матір-природу часто забувають. Могутня сила цього простого середньовічного зілля та перелік його компонентів показують, що наука та природа нерозривно пов'язані.
Джерело: https://kulturologia.ru/blogs/030920/47424/
Источник: zefirka.net



